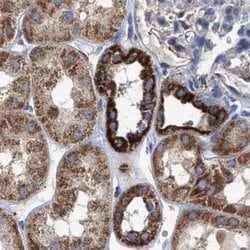
Invitrogen MECR Polyclonal Antibody 100 &mu;L | Buy Online | Invitrogen&trade; | Fisher Scientific

missing translation for 'onlineSavingsMsg'
Learn More
Learn More
Description
Immunogen sequence: SDIPLQSAAT LGVNPCTAYR MLMDFEQLQP GDSVIQNASN SGVGQAVIQI AAALGLRTIN VVRDRPDIQK LSDRLKSLGA EHVITEEELR RPEMKNFFKD MPQPRLALNC V Highest antigen sequence identity to the following orthologs: Mouse - 85%, Rat - 86%.
The mitochondrial trans-2-enoyl-CoA reductase (MECR), was initially identified as nuclear receptor-binding factor 1 (NRBF1), which can interact with a multitude of nuclear hormone receptors in the presence of the respective ligands. MECR has been shown to be part of the mitochondrial fatty acid synthesis (FAS II) system and to catalyze the NAPDH-dependent reduction of 2-enoyl thioesters, generating saturated acyl-groups. Overexpression of this gene in transgenic mice can lead to cardiac abnormalities, suggesting that inappropriate expression of genes of FAS II can result in the development of hereditary cardiomyopathy.

Specifications
Specifications
| Antigen | MECR |
| Applications | Immunohistochemistry (Paraffin), Western Blot |
| Classification | Polyclonal |
| Concentration | 0.2 mg/mL |
| Conjugate | Unconjugated |
| Formulation | PBS with 40% glycerol and 0.02% sodium azide; pH 7.2 |
| Gene | Mecr |
| Gene Accession No. | Q9BV79 |
| Gene Alias | 2-enoyl thioester reductase; AI195831; CGI-63; Enoyl-[acyl-carrier-protein] reductase, mitochondrial; FASN2B; homolog of yeast 2-enoyl thioester reductase; HsNrbf-1; Mecr; mitochondrial 2-enoyl thioester reductase; mitochondrial trans-2-enoyl-CoA reductase; NBRF1; Nrbf1; NRBF-1; nuclear receptor binding factor 1; nuclear receptor-binding factor 1; trans-2-enoyl-CoA reductase, mitochondrial |
| Gene Symbols | Mecr |
| Show More |
Product Title
By clicking Submit, you acknowledge that you may be contacted by Fisher Scientific in regards to the feedback you have provided in this form. We will not share your information for any other purposes. All contact information provided shall also be maintained in accordance with our Privacy Policy.
Spot an opportunity for improvement?